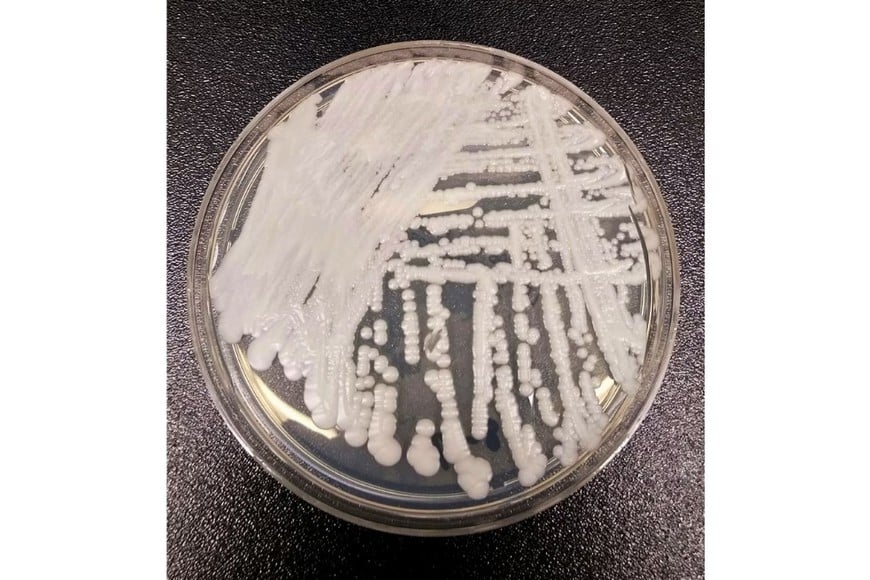
El hongo Candida auris, considerado uno de los patógenos emergentes más preocupantes

El hongo Candida auris, considerado uno de los patógenos emergentes más preocupantes en hospitales de todo el mundo, podría tener un punto débil científicamente identificable para diseñar tratamientos más eficaces.
Hallan una posible vía para combatir el hongo hospitalario Candida auris, resistente y letal
Especialistas de Reino Unido y Países Bajos identifican un punto débil genético del hongo Candida auris, que pone en jaque a los sistemas de salud por su alta mortalidad y resistencia a tratamientos. El avance podría allanar el camino a nuevas estrategias de control y terapias dirigidas.

Investigadores del Reino Unido y Países Bajos lograron descifrar cómo este microorganismo capta hierro durante la infección, una clave para su supervivencia dentro del organismo, y proponen bloquear ese mecanismo como posible vía terapéutica en el futuro.
Un enemigo silencioso dentro de los hospitales
Candida auris fue detectado por primera vez en 2008 y desde entonces se ha convertido en una amenaza creciente, especialmente en ambientes sanitarios.
Este hongo puede colonizar superficies, equipos médicos y la piel humana, y causar infecciones muy graves en pacientes inmunocomprometidos o en estado crítico.
Su capacidad de resistir múltiples clases de antifúngicos lo convierte en un desafío formidable para los servicios de salud.
Según los primeros estudios, la mortalidad asociada a infecciones invasivas por Candida auris puede rondar el 45%, un porcentaje alarmante que lo ubica entre los agentes infecciosos de mayor impacto en pacientes hospitalizados.
La Organización Mundial de la Salud ya ha catalogado a este hongo entre los patógenos más preocupantes, lo que ha impulsado a grupos científicos internacionales a concentrar esfuerzos en comprender su biología y mecanismos de virulencia para hallar estrategias de intervención más eficaces.

Nueva diana terapéutica
El estudio publicado recientemente en la revista Communications Biology identifica genes que se activan durante la infección y permiten que Candida auris extraiga hierro, un mineral esencial para su crecimiento y proliferación.
Sin hierro, el hongo no puede sobrevivir, lo que convierte a este proceso en un objetivo potencial para el desarrollo de nuevos fármacos.
“Descubrimos qué genes se activan en el hongo durante la infección dentro de un organismo vivo y cómo le permiten captar hierro”, explicó el doctor Rhys Farrer, líder del estudio y experto en bioinformática del Centro de Micología Médica de la Universidad de Exeter.
Para observar al patógeno en acción, los científicos utilizaron larvas de pez killi árabe, un modelo biológico que soporta temperaturas corporales humanas.
Estas observaciones en tiempo real mostraron cómo el hongo pasa de una forma inocua a filamentos que buscan activamente hierro dentro del huésped, lo que facilita la infección.
Bloquear la captación de hierro podría, en teoría, debilitar al hongo e impedir su crecimiento, pero aún se necesita validar estos hallazgos en modelos más cercanos al cuerpo humano antes de aplicarlos en ensayos clínicos.

El contexto global de una amenaza silenciosa
La alarma por Candida auris no es menor: su propagación en hospitales ha sido documentada en más de 40 países, y varios focos de infección han obligado al cierre temporal de unidades de cuidados intensivos y salas de terapia intensiva.
En Argentina, recientemente se confirmaron los primeros casos de Candida auris, detectados en pacientes internados en una clínica de Buenos Aires, según informó el Ministerio de Salud.
Estos dos casos se dieron en personas con sistemas inmunitarios debilitados, un patrón que coincide con lo observado a nivel internacional.
Además, organismos sanitarios internacionales como el Centro Europeo para la Prevención y el Control de Enfermedades (ECDC) han advertido sobre la rápida expansión de este hongo resistente en hospitales de varios países europeos, donde continúa propagándose y dificultando los esfuerzos de control.
Este hongo representa un doble desafío: por un lado, su resistencia natural a muchos de los antifúngicos disponibles; por el otro, la capacidad de sobrevivir en superficies y mecanismos hospitalarios, lo que facilita su transmisión entre pacientes, profesionales de la salud y visitantes.
El aumento de infecciones invasivas por hongos resistentes es parte de una tendencia global que preocupa a especialistas en enfermedades infecciosas y microbiología médica.
La resistencia fúngica está en aumento y complica cada vez más el tratamiento de infecciones que antes podían ser controladas con medicamentos convencionales.

¿Qué sigue en la investigación?
Aunque los descubrimientos actuales son prometedores, los científicos insisten en que aún falta avanzar en estudios preclínicos y ensayos controlados para evaluar si el bloqueo de la captación de hierro es realmente eficaz y seguro en humanos.
Si bien ya existen fármacos que interfieren con la absorción de hierro, su aplicación contra Candida auris requerirá un desarrollo específico y cuidadoso.








